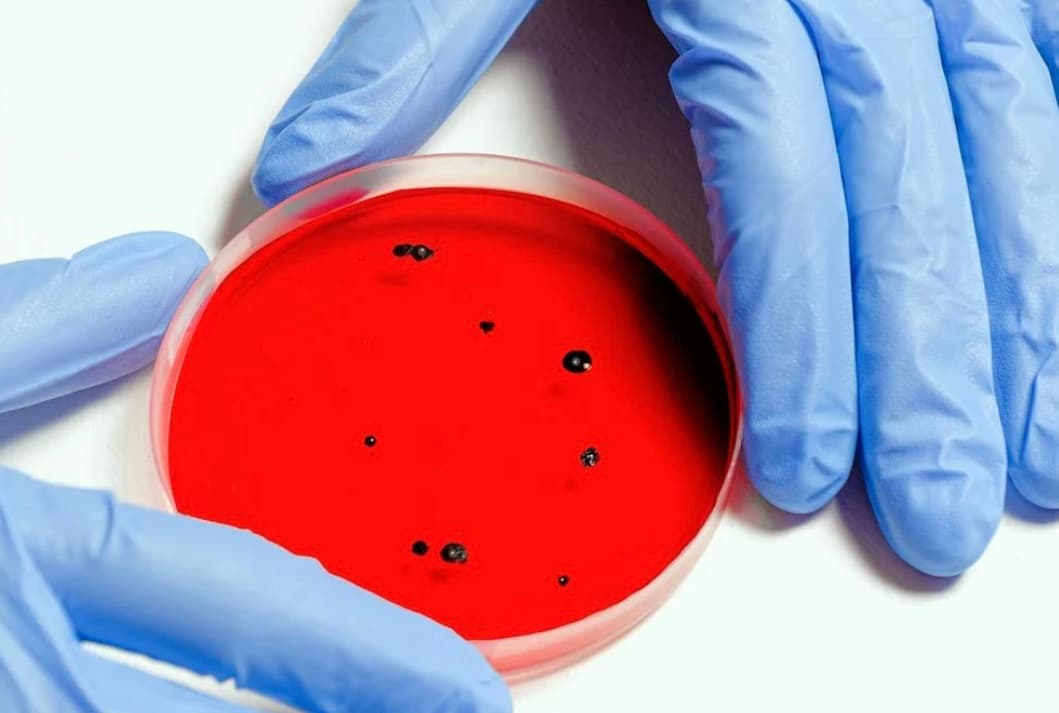
b-667120251125182946294.jpg

BONTANG — Standar Pelayanan Minimal (SPM) Kota Bontang untuk tahun 2023 rata-rata mencapai 92,48 persen.
Berdasarkan data yang diterima dari Pemerintah Kota (Pemkot) Bontang, dikutip katakaltim Minggu (27/10/2024), standar pelayanan di sektor kesehatan menduduki persentase paling rendah, yaitu 77,67.
Berikut ini pelayanan dasar di Kota Bontang berdasarkan urutan tertinggi persentase.
1. Pelayanan dasar urusan sosial 100 persen;
2. Pelayanan dasar urusan perumahan rakyat 100 persen;
3. Pelayanan dasar urusan ketertiban umum 99,02 persen;
4. Pelayanan dasar urusan pendidikan 96,60 persen;
5. Pelayanan dasar urusan pekerjaan umum 81,62 persen;
6. Pelayanan dasar urusan kesehatan 77,67 persen.
Untuk triwulan pertama seperti data yang tertera, SPM kesehatan masih berada di persentase 45,40. Sementara pekerjaan umum capai 87,07 persen. (*)